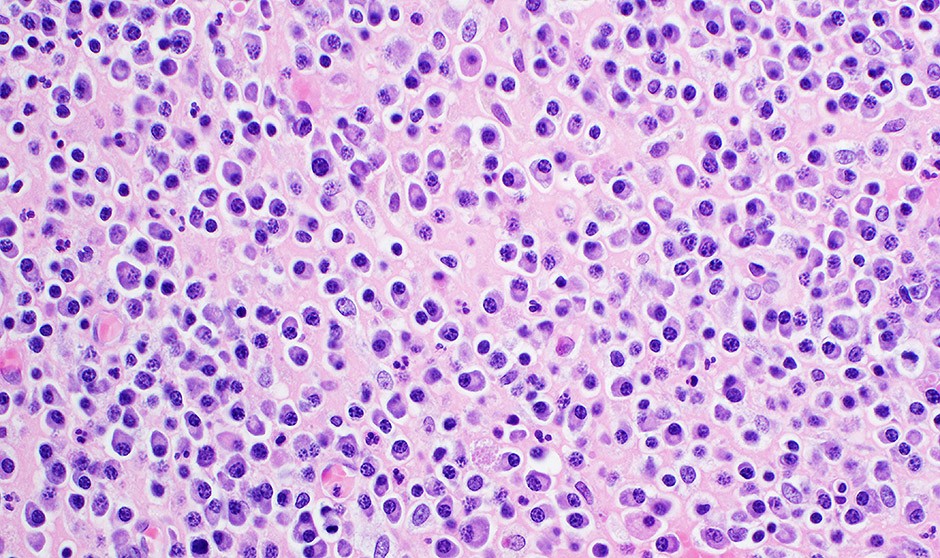
La micolactona logra la muerte celular selectiva contra el mieloma múltiple

Los investigadores han logrado este descubrimiento mientras analizaban una enfermedad diferente, denominada la úlcera de Buruli.
Un estudio descubre un nuevo mecanismo que 'asesina' de forma programada las células del
mieloma múltiple. El bloqueo de la secretasa 61 (
Sec61) por
micolactona induce muerte celular selectiva en este tipo de cáncer. Los hallazgos identifican a Sec61 como una vulnerabilidad terapéutica en el mieloma múltiple y, potencialmente, en todos los demás tipos de cáncer que necesitan un translocón Sec61 activo para sobrevivir.
En esta misma línea, los investigadores del estudio, publicado en la revista médica
EMBO Molecular Medicine, sugieren que
tratar a los pacientes con mieloma múltiple con agentes que bloquean Sec61 aumentará la eficacia de las quimioterapias actuales y superará la resistencia a ellas.
Los cientientíficos del Institut Pasteur/Inserm (París, Francia) han logrado este descubrimiento mientras analizaban una enfermedad diferente, denominada la úlcera de
Buruli, que es una patología tropical desatendida, causada por la infección con una bacteria (Mycobacterium ulcerans).
Caroline Demangel, jefa de la Unidad de Inmunobiología de las Infecciones del Institut Pasteur, ha explicado que "este estudio proporciona la prueba de concepto de que el translocon es una nueva diana terapéutica en el mieloma múltiple. El próximo paso será identificar moléculas similares a fármacos que inhiban Sec61, lo que podría constituir un nuevo tratamiento para este cáncer. Además, nuestro objetivo es estudiar si esta diana podría ser común a otros cánceres".
Micolactona, altamente tóxica para las células de mieloma múltiple
El grupo descubrió cómo la toxina micolactona provoca las manifestaciones clínicas de la úlcera de
Buruli: al actuar sobre el translocón (Sec61). Así pues, demostraron que
la micolactona es altamente tóxica para las células de mieloma múltiple, incluidas aquellas que se han vuelto resistentes a los inhibidores del proteasoma, en dosis que no son tóxicas para las células normales.
Además, demostraron que los inhibidores de la micolactona y del proteasoma funcionan en sinergia, potenciando mutuamente sus efectos anticancerígenos.
|
"Mostramos que la micolactona potencia la actividad de los fármacos que forman la columna vertebral de la quimio"
|
En cuanto al desarrollo del proceso, Demangel señala que "las células humanas interactúan con su entorno a través de proteínas que se expresan en su superficie o se secretan en el entorno extracelular. El proceso de entrega de estas proteínas a la pared de la membrana o al exterior, la vía de secreción, utiliza una red de distribución dedicada cuya puerta de enlace es el translocón Sec61".
Además, añade que "recientemente descubrimos que la
micolactona, una toxina producida por un patógeno bacteriano, actúa bloqueando Sec61. Usando micolactona, demostramos en el presente estudio que
el bloqueo de Sec61 es mucho más tóxico para las células de mieloma múltiple que para las células normales in vitro e in vivo".
En definitiva, "mostramos que la micolactona potencia la actividad de los fármacos que forman la columna vertebral de las quimioterapias actuales para el mieloma múltiple", concluye Demangel.
Las informaciones publicadas en Redacción Médica contienen afirmaciones, datos y declaraciones procedentes de instituciones oficiales y profesionales sanitarios. No obstante, ante cualquier duda relacionada con su salud, consulte con su especialista sanitario correspondiente.